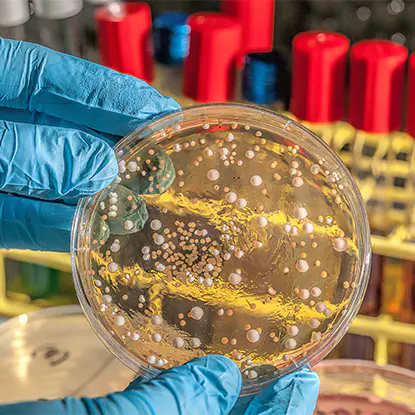
Health and Disease Control

[ Our Solutions ]
Industries We
Serve
Our products are used in a wide range of industries, supporting consistent quality improvement.
Our
 Categories
Categories

Complete series of laboratory equipment meeting precise experimental needs across different industries
[ Who We Are ]
About Dengsheng Instrument Professional Laboratory Equipment
Manufacturer
Shanghai Dengsheng Instrument Manufacturing Co., Ltd. is a high-tech enterprise integrating R&D, production, sales, and service. We specialize in the manufacture of high-end laboratory equipment,
including ovens, incubators, industrial furnaces, and environmental test chambers.
We boast an 8,000-square-meter modern production facility, a dedicated R&D team, 23 national patents, and ISO-9001 quality management system certification. As
We boast an 8,000-square-meter modern production facility, a dedicated R&D team, 23 national patents, and ISO-9001 quality management system certification. As
Laboratory Equipment Manufacturers and Lab Equipment Suppliers in China
, Our solutions are widely used in cutting-edge fields such as aerospace, semiconductors, biomedicine, automotive, and new materials. We have established in-depth partnerships with top universities and industry leaders, and our products are exported to many countries and regions around the world.-
0+Factory Area
-
0Employees
-
0+Cooperating Customers
-
0+Patents
[ Our Strength ]
High-Tech Enterprise, Reliable Lab Equipment Partner
With a modern production base of over 8,000 sqm, a dedicated R&D team, and 23 national patents, Shanghai Dengsheng Instrument is committed to providing high-performance laboratory equipment and environmental testing solutions, from standard to custom. We drive innovation, build on
quality, and serve global scientific research and industrial fields.
-
 Collaboration & Global Vision
Collaboration & Global Vision -
 Products & Applications
Products & Applications -
 Manufacturing & Quality
Manufacturing & Quality -
 R&D & Innovation
R&D & Innovation
[ Our Blogs ]
Explore Our
Latest Post


 Español
Español  عربى
عربى